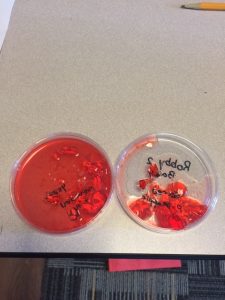
JelloLab

Day 3 in Culinary Chemistry and it was on to Dr. Loren’s favorite biomolecule: PROTEIN!

In the morning we learned about how proteins fold and unfold when we cook our food and how they function in our body. We learned that proteins are a string of amino acids that have unique properties that allow them to fold. Then we acted out a protein as it folds and the students each represented an amino acid. In the afternoon we did an experiment to analyze protein unfolding (also called denaturation) which is what happens when we cook our food. Pineapple has a protein called bromelain that denatures meat protein so we used fresh pineapple juice and jello (which contains gelatin, a meat protein) to see if it would break down.
On the flip side, we used canned pineapple juice to compare. The canned pineapple juice probably has dysfunctional bromelain because it has been through the cooking and preserving process. The reaction was slow moving so we can’t wait to analyze and discuss tomorrow!